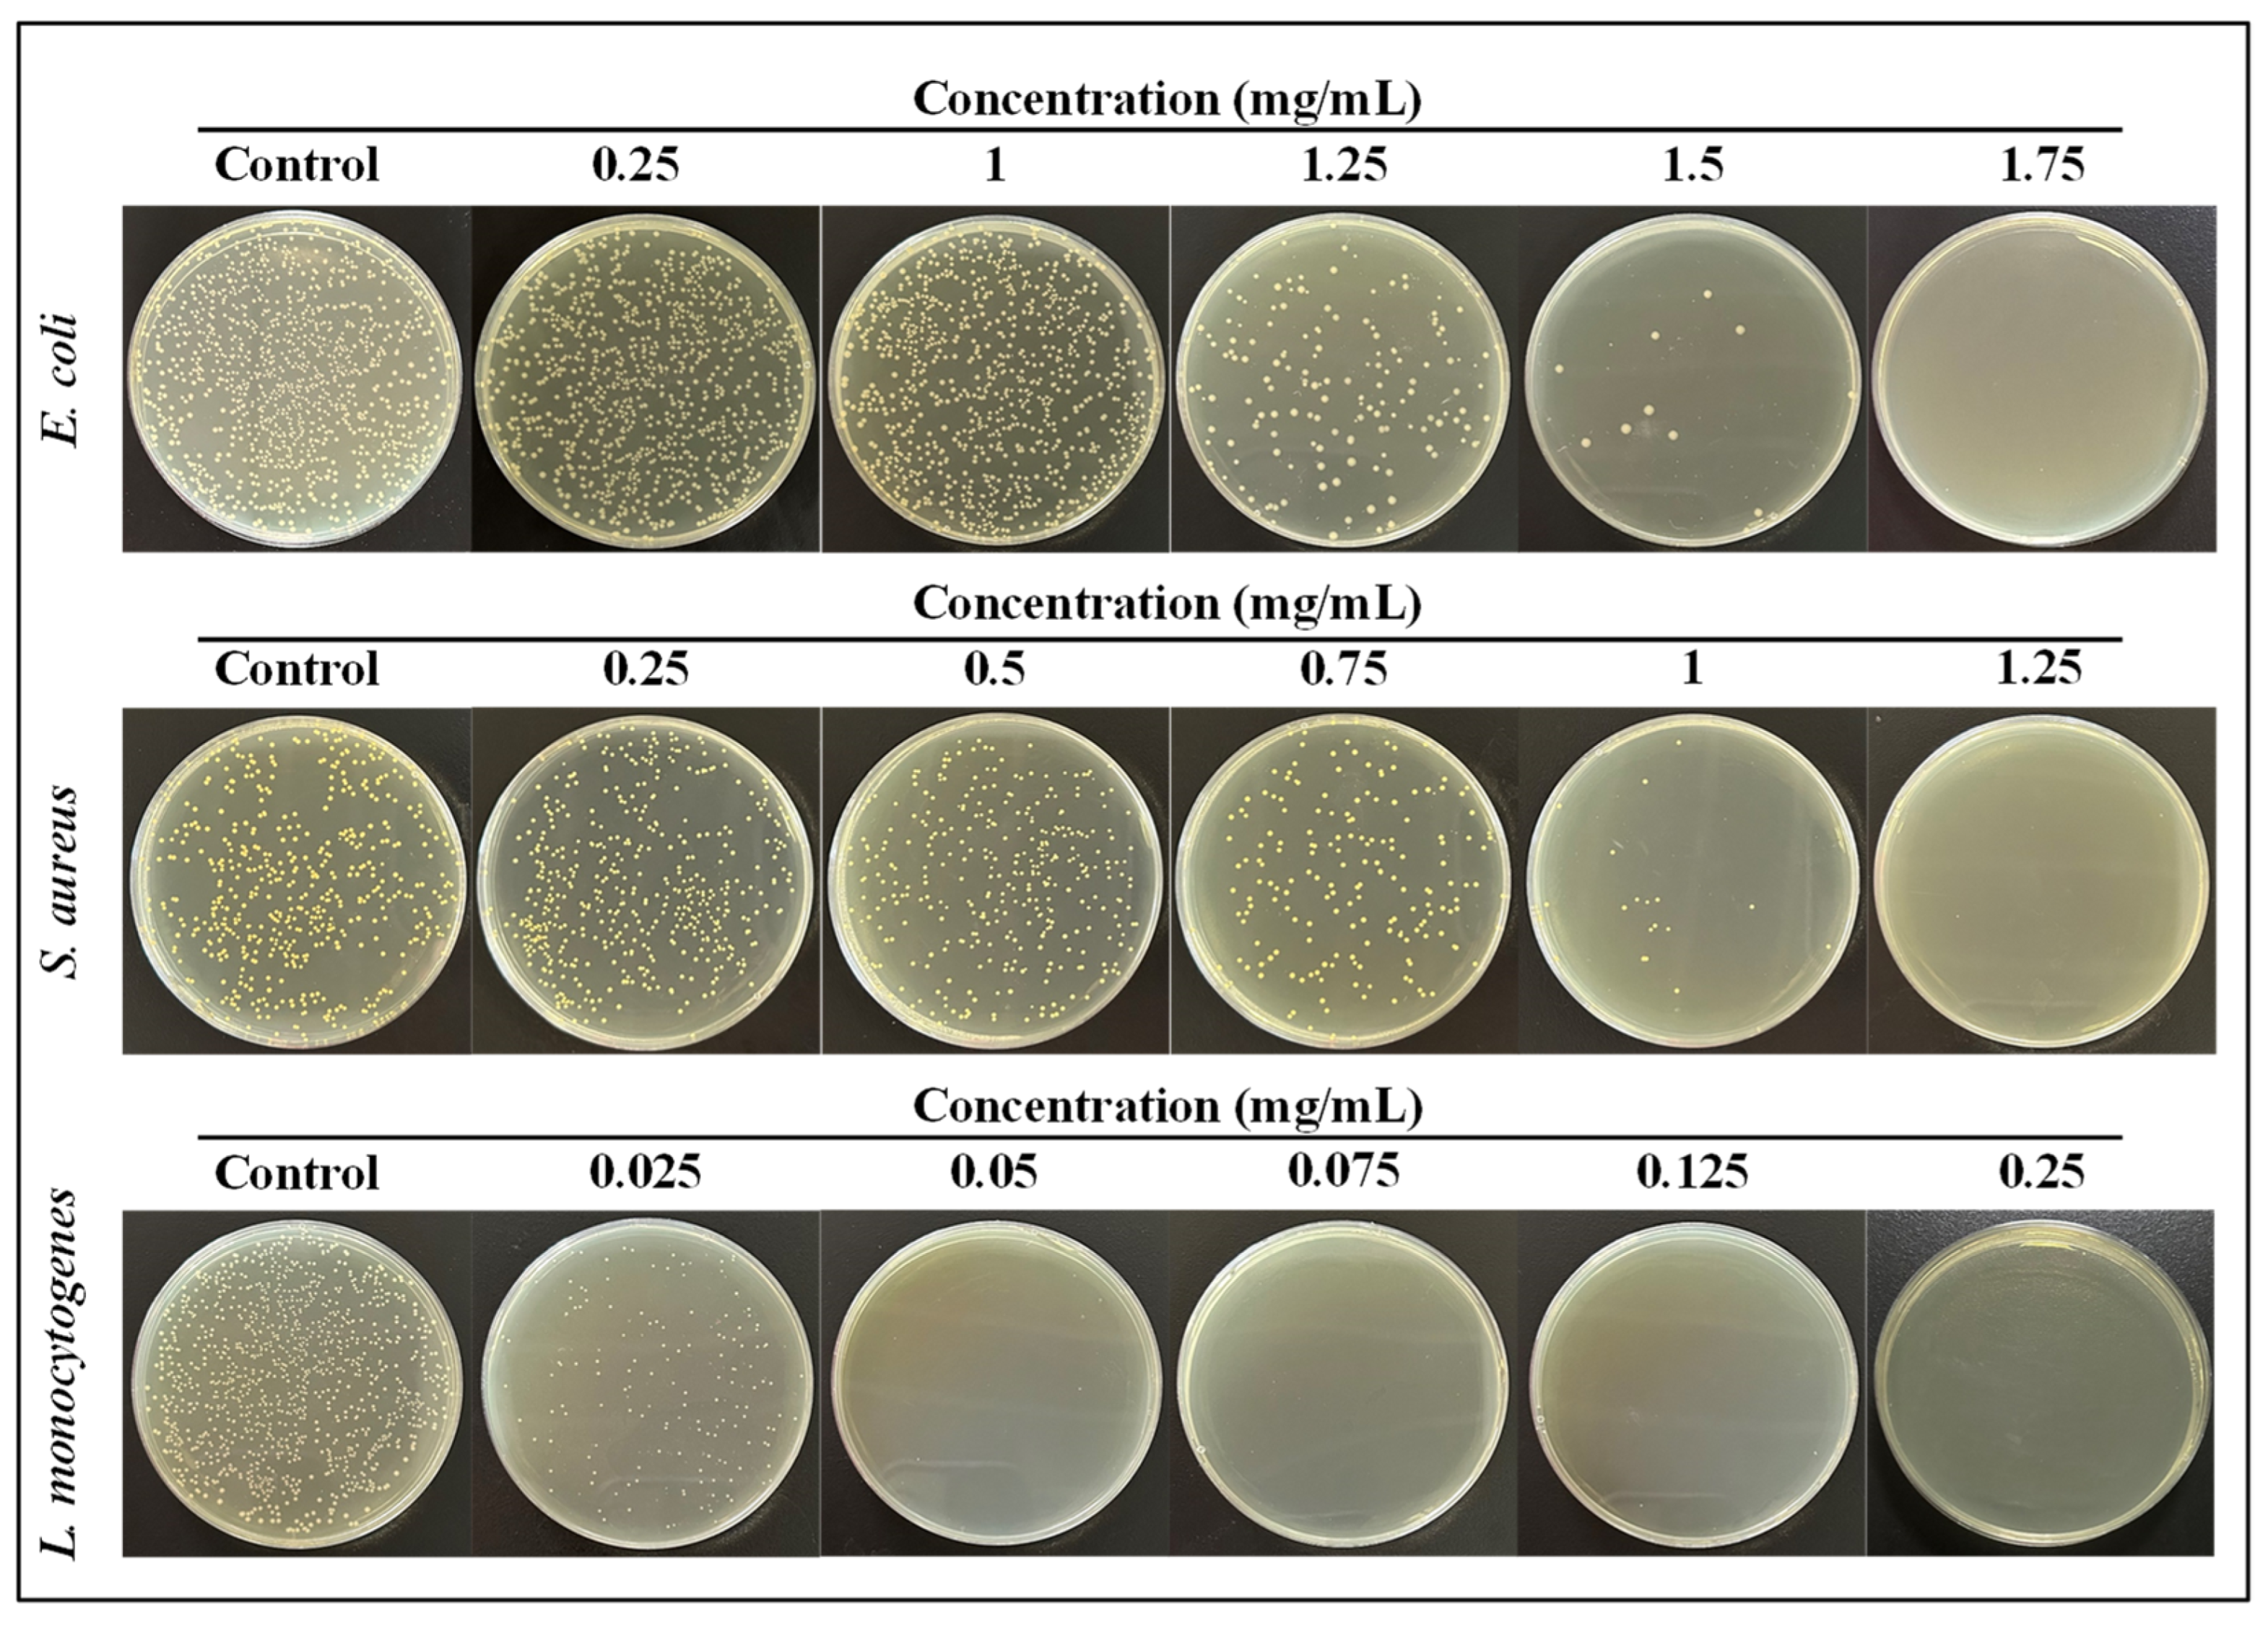
Nanomaterials 13 01416 g006 Nanomaterials 13 01416 g006

Gentamicin Sulfate Grafted Magnetic GO Nanohybrids with Excellent Antibacterial Properties and Recyclability
Abstract
1. Introduction
2. Materials and Methods
2.1. Materials
2.2. GS-MGO Preparation
2.3. Characterization
2.4. Antibacterial Activity
2.4.1. Disk Diffusion Analysis
2.4.2. Antibacterial Growth Effect
2.4.3. Plate Count Method
2.5. Recyclable Activity
2.6. Protein Leakage
3. Results and Discussion
3.1. Characterization
3.2. Antibacterial Performance
3.3. Recyclable Activity
3.4. Protein Leakage Analysis
4. Conclusions
Author Contributions
Funding
Data Availability Statement
Conflicts of Interest
References
- Ameh, T.; Zarzosa, K.; Dickinson, J.; Braswell, W.E.; Sayes, C.M. Nanoparticle surface stabilizing agents influence antibacterial action. Front. Microbiol. 2023, 14, 1119550. [Google Scholar] [CrossRef] [PubMed]
- Qi, G.; Hu, F.; Kenry, K.; Shi, L.; Wu, M.; Liu, B. An AIEgen-Peptide Conjugate as a Phototheranostic Agent for Phagosome-Entrapped Bacteria. Angew. Chem. Int. Ed. 2019, 58, 16229–16235. [Google Scholar] [CrossRef]
- Aashima; Pandey, S.K.; Singh, S.; Mehta, S. Biocompatible gadolinium oxide nanoparticles as efficient agent against pathogenic bacteria. J. Colloid Interface Sci. 2018, 529, 496–504. [Google Scholar] [CrossRef]
- Jiang, L.; Zhu, Z.; Wen, Y.; Ye, S.; Su, C.; Zhang, R.; Shao, W. Facile Construction of Functionalized GO Nanocomposites with Enhanced Antibacterial Activity. Nanomaterials 2019, 9, 913. [Google Scholar] [CrossRef] [PubMed]
- Spesia, M.B.; Durantini, E.N. Evolution of Phthalocyanine Structures as Photodynamic Agents for Bacteria Inactivation. Chem. Rec. 2022, 22, e202100292. [Google Scholar] [CrossRef]
- Zhou, X.-M.; Hu, Y.-Y.; Fang, B.; Zhou, C.-H. Benzenesulfonyl thiazoloimines as unique multitargeting antibacterial agents towards Enterococcus faecalis. Eur. J. Med. Chem. 2023, 248, 115088. [Google Scholar] [CrossRef] [PubMed]
- Chang, R.Y.K.; Nang, S.C.; Chan, H.-K.; Li, J. Novel antimicrobial agents for combating antibiotic-resistant bacteria. Adv. Drug Deliv. Rev. 2022, 187, 114378. [Google Scholar] [CrossRef] [PubMed]
- Giebułtowicz, J.; Tyski, S.; Wolinowska, R.; Grzybowska, W.; Zaręba, T.; Drobniewska, A.; Wroczyński, P.; Nałęcz-Jawecki, G. Occurrence of antimicrobial agents, drug-resistant bacteria, and genes in the sewage-impacted Vistula River (Poland). Environ. Sci. Pollut. Res. 2017, 25, 5788–5807. [Google Scholar] [CrossRef]
- Dai, T.; Guo, B.; Qi, G.; Xu, S.; Zhou, C.; Bazan, G.C.; Liu, B. An AIEgen as an Intrinsic Antibacterial Agent for Light-Up Detection and Inactivation of Intracellular Gram-Positive Bacteria. Adv. Health Mater. 2021, 10, e2100885. [Google Scholar] [CrossRef]
- Pereira, P.; Ferreira, D.P.; Araújo, J.C.; Ferreira, A.; Fangueiro, R. The Potential of Graphene Nanoplatelets in the Development of Smart and Multifunctional Ecocomposites. Polymers 2020, 12, 2189. [Google Scholar] [CrossRef]
- González, Z.; Acevedo, B.; Predeanu, G.; Axinte, S.M.; Drăgoescu, M.-F.; Slăvescu, V.; Fernandez, J.J.; Granda, M.; Gryglewicz, G.; Melendi-Espina, S. Graphene materials from microwave-derived carbon precursors. Fuel Process. Technol. 2021, 217, 106803. [Google Scholar] [CrossRef]
- Umar, A.; Kumar, S.A.; Inbanathan, S.; Modarres, M.; Kumar, R.; Algadi, H.; Ibrahim, A.A.; Wendelbo, R.; Packiaraj, R.; Alhamami, M.A.; et al. Enhanced sunlight-driven photocatalytic, supercapacitor and antibacterial applications based on graphene oxide and magnetite-graphene oxide nanocomposites. Ceram. Int. 2022, 48, 29349–29358. [Google Scholar] [CrossRef]
- Li, Y.; Yang, D.; Cui, J. Graphene oxide loaded with copper oxide nanoparticles as an antibacterial agent against Pseudomonas syringae pv. tomato. RSC Adv. 2017, 7, 38853–38860. [Google Scholar] [CrossRef]
- Rajapaksha, P.; Orrell-Trigg, R.; Shah, D.; Cheeseman, S.; Vu, K.; Ngo, S.; Murdoch, B.; Choudhury, N.; Yin, H.; Cozzolino, D.; et al. Broad spectrum antibacterial zinc oxide-reduced graphene oxide nanocomposite for water depollution. Mater. Today Chem. 2023, 27, 101242. [Google Scholar] [CrossRef]
- Dat, N.; Thinh, D.; Huong, L.; Tinh, N.; Linh, N.; Hai, N.; Viet, N.; Phong, M.; Hieu, N. Facile synthesis and antibacterial activity of silver nanoparticles-modified graphene oxide hybrid material: The assessment, utilization, and anti-virus potentiality. Mater. Today Chem. 2022, 23, 100738. [Google Scholar] [CrossRef]
- Zou, J.; Bao, D.; Ma, R.; Zhu, Z.; Chen, X.; Zhu, J.; Fan, X.; Zhang, K.; Zheng, H.; Li, F.; et al. Green and Sustainable Self-Assembly Nanocomposite from Gentamicin Sulfate/Lignosulfonate with Efficient Antibacterial and Wound-Healing Activity. ACS Sustain. Chem. Eng. 2020, 8, 4931–4940. [Google Scholar] [CrossRef]
- Liu, Y.; Ji, P.; Lv, H.; Qin, Y.; Deng, L. Gentamicin modified chitosan film with improved antibacterial property and cell biocompatibility. Int. J. Biol. Macromol. 2017, 98, 550–556. [Google Scholar] [CrossRef]
- Rehman, M.S.U.; Raza, Z.A.; Rehan, Z.A.; Bakhtiyar, M.J.; Sharif, F.; Yousaf, M. Citric acid crosslinked biocompatible silk fibroin-mediated porous chitosan films for sustained drug release application. Mater. Today Commun. 2023, 34, 105373. [Google Scholar] [CrossRef]
- Jiang, L.; Su, C.; Wen, Y.; Zhu, Z.; Liu, J.; He, S.; He, S.; Liu, X.; Shao, W. Antibacterial activity and long-term stable antibacterial performance of nisin grafted magnetic GO nanohybrids. Mater. Sci. Eng. C 2020, 111, 110809. [Google Scholar] [CrossRef]
- Lu, W.; Li, J.; Sheng, Y.; Zhang, X.; You, J.; Chen, L. One-pot synthesis of magnetic iron oxide nanoparticle-multiwalled carbon nanotube composites for enhanced removal of Cr(VI) from aqueous solution. J. Colloid Interface Sci. 2017, 505, 1134–1146. [Google Scholar] [CrossRef]
- Liang, Q.; Liu, L.; Wu, Z.; Nie, H.; Shi, H.; Li, Z.; Kang, Z. Polytriptycene@CdS double shell hollow spheres with enhanced interfacial charge transfer for highly efficient photocatalytic hydrogen evolution. J. Mater. Chem. A 2021, 9, 9105–9112. [Google Scholar] [CrossRef]
- Du, T.; Huang, B.; Cao, J.; Li, C.; Jiao, J.; Xiao, Z.; Wei, L.; Ma, J.; Du, X.; Wang, S. Ni Nanocrystals Supported on Graphene Oxide: Antibacterial Agents for Synergistic Treatment of Bacterial Infections. ACS Omega 2022, 7, 18339–18349. [Google Scholar] [CrossRef] [PubMed]
- Geng, C.; Zhao, F.; Wang, Q.; Zheng, S.; Liu, Y.; Niu, H.; Zhang, J.; Dong, H. Anti-biofouling property and anti-leaching investigation of modifier for PVDF ultrafiltration membrane by incorporating antibacterial graphene oxide derivatives. J. Environ. Chem. Eng. 2022, 10, 108558. [Google Scholar] [CrossRef]
- Railian, S.; Fadil, Y.; Agarwal, V.; Junkers, T.; Zetterlund, P.B. Synthesis of electrically conducting nanocomposites via Pickering miniemulsion polymerization: Effect of graphene oxide functionalized with different capping agents. Eur. Polym. J. 2022, 178, 111498. [Google Scholar] [CrossRef]
- Ocsoy, I.; Temiz, M.; Celik, C.; Altinsoy, B.; Yilmaz, V.; Duman, F. A green approach for formation of silver nanoparticles on magnetic graphene oxide and highly effective antimicrobial activity and reusability. J. Mol. Liq. 2017, 227, 147–152. [Google Scholar] [CrossRef]
- Li, T.; Wang, M.; Hou, Q.; Hou, Y.; Xuan, K.; Hao, Y. Visible-light-enhanced-hydrophilicity promoted adsorption-photodegradation of phenanthrene with core-shell Fe3O4@SiO2@N-TiO2 loaded on graphene oxide. Appl. Surf. Sci. 2022, 605, 154672. [Google Scholar] [CrossRef]
- Li, T.; Wang, M.; Hao, Y. Highly efficient photodegradation of magnetic GO-Fe3O4@SiO2@CdS for phenanthrene and pyrene: Mechanism insight and application assessment. Sci. Total Environ. 2023, 857, 159254. [Google Scholar] [CrossRef]
- Hashemi, S.A.; Mousavi, S.M.; Bahrani, S.; Gholami, A.; Chiang, W.-H.; Yousefi, K.; Omidifar, N.; Rao, N.V.; Ramakrishna, S.; Babapoor, A.; et al. Bio-enhanced polyrhodanine/graphene Oxide/Fe3O4 nanocomposite with kombucha solvent supernatant as ultra-sensitive biosensor for detection of doxorubicin hydrochloride in biological fluids. Mater. Chem. Phys. 2022, 279, 125743. [Google Scholar] [CrossRef]
- Wang, T.; Bai, Z.; Wei, W.; Hou, F.; Guo, W.; Wei, A. beta-Cyclodextrin-Derivative-Functionalized Graphene Oxide/Graphitic Carbon Nitride Composites with a Synergistic Effect for Rapid and Efficient Sterilization. ACS Appl. Mater. Interfaces 2022, 14, 474–483. [Google Scholar] [CrossRef]
- Yang, H.M.; Jo, S.; Oh, J.H.; Choi, B.-H.; Woo, J.Y.; Han, C.-S. Strong and Tough Nacre-Inspired Graphene Oxide Composite with Hierarchically Similar Structure. ACS Nano 2022, 16, 10509–10516. [Google Scholar] [CrossRef]
- Kaczmarek-Szczepańska, B.; Michalska-Sionkowska, M.; Binkowski, P.; Lukaszewicz, J.P.; Kamedulski, P. 3D-Structured and Blood-Contact-Safe Graphene Materials. Int. J. Mol. Sci. 2023, 24, 3576. [Google Scholar] [CrossRef] [PubMed]
- Liu, Y.; Zhou, Y.; Zhu, P.; Luo, X.; Chen, J.; Li, Y.; Qiu, Q.; Xie, T. Surfactant-assisted synthesis of highly dispersed ZnS(C) /BiOBr/GO ternary composites for effectively improve the degradation ability of organic pollutants under visible light. J. Mol. Liq. 2023, 378, 121621. [Google Scholar] [CrossRef]
- Liu, W.; Wang, Z.; Yan, W.; Zhao, Z.; Shi, L.; Huang, L.; Liu, Y.; He, X.; Cui, S. Construction of ultra-sensitive surface-enhanced Raman scattering substrates based on 3D graphene oxide aerogels. Carbon 2023, 202, 389–397. [Google Scholar] [CrossRef]

Disclaimer/Publisher’s Note: The statements, opinions and data contained in all publications are solely those of the individual author(s) and contributor(s) and not of MDPI and/or the editor(s). MDPI and/or the editor(s) disclaim responsibility for any injury to people or property resulting from any ideas, methods, instructions or products referred to in the content. |
© 2023 by the authors. Licensee MDPI, Basel, Switzerland. This article is an open access article distributed under the terms and conditions of the Creative Commons Attribution (CC BY) license (https://creativecommons.org/licenses/by/4.0/).
Share and Cite
Wu, X.; Zhou, J.; Liu, Z.; Shao, W. Gentamicin Sulfate Grafted Magnetic GO Nanohybrids with Excellent Antibacterial Properties and Recyclability. Nanomaterials 2023, 13, 1416. https://doi.org/10.3390/nano13081416
Wu X, Zhou J, Liu Z, Shao W. Gentamicin Sulfate Grafted Magnetic GO Nanohybrids with Excellent Antibacterial Properties and Recyclability. Nanomaterials. 2023; 13(8):1416. https://doi.org/10.3390/nano13081416
Chicago/Turabian StyleWu, Xing, Jingya Zhou, Zeng Liu, and Wei Shao. 2023. "Gentamicin Sulfate Grafted Magnetic GO Nanohybrids with Excellent Antibacterial Properties and Recyclability" Nanomaterials 13, no. 8: 1416. https://doi.org/10.3390/nano13081416
APA StyleWu, X., Zhou, J., Liu, Z., & Shao, W. (2023). Gentamicin Sulfate Grafted Magnetic GO Nanohybrids with Excellent Antibacterial Properties and Recyclability. Nanomaterials, 13(8), 1416. https://doi.org/10.3390/nano13081416
